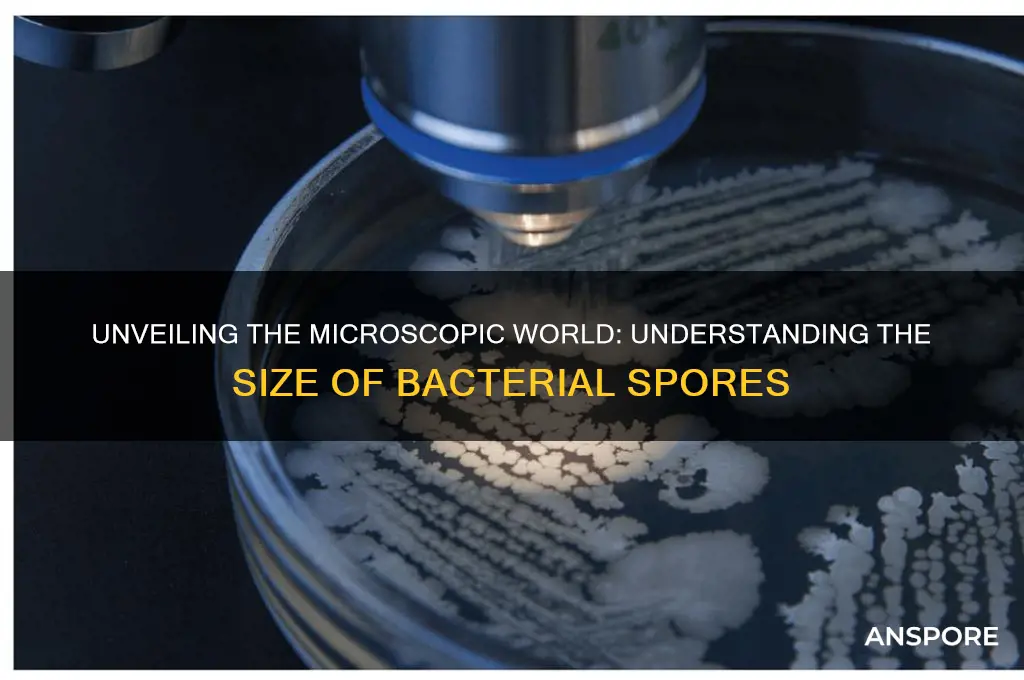
how big are bacterial spores

Bacterial spores are highly resistant, dormant structures produced by certain bacteria as a survival mechanism in unfavorable conditions. Their size varies depending on the bacterial species, but they are generally small, typically ranging from 0.5 to 1.5 micrometers in diameter. This compact size allows them to remain suspended in air, water, or soil for extended periods, enhancing their ability to disperse and survive extreme environments such as heat, desiccation, and chemicals. Despite their small size, bacterial spores pose significant challenges in sterilization processes due to their remarkable resilience.
| Characteristics | Values |
|---|---|
| Size (Diameter) | 0.5 to 1.5 micrometers (μm) |
| Shape | Typically oval or spherical |
| Wall Thickness | 20 to 50 nanometers (nm) |
| Density | Higher than vegetative cells |
| Resistance | Highly resistant to heat, desiccation, radiation, and chemicals |
| Core Composition | DNA, RNA, enzymes, and dipicolinic acid (DPA) |
| Outer Layer | Exosporium (in some species), spore coat, and cortex |
| Metabolic Activity | Dormant (no active metabolism) |
| Lifespan | Can remain viable for years to centuries |
| Germination Time | Hours to days, depending on conditions |
| Examples of Species | Bacillus anthracis, Clostridium botulinum, Sporosarcina pasteurii |
Explore related products
What You'll Learn
- Spore Size Range: Bacterial spores typically measure 0.5 to 1.5 micrometers in diameter
- Species Variation: Spore size varies among bacterial species, influenced by genetics and environment
- Measurement Methods: Techniques like microscopy and flow cytometry are used to determine spore size
- Size and Survival: Smaller spores often exhibit greater resistance to environmental stresses
- Comparative Analysis: Bacterial spores are generally smaller than fungal spores but larger than viruses

Spore Size Range: Bacterial spores typically measure 0.5 to 1.5 micrometers in diameter
Bacterial spores, the dormant and highly resilient forms of certain bacteria, are remarkably small yet play a significant role in microbial survival. Their size typically ranges from 0.5 to 1.5 micrometers in diameter, a dimension that is both a survival advantage and a challenge for detection. To put this into perspective, a human hair is approximately 75 micrometers wide, making bacterial spores invisible to the naked eye and nearly 50 to 150 times smaller than this everyday object. This minuscule size allows spores to remain suspended in air for extended periods, increasing their chances of dispersal and survival in harsh environments.
Understanding the size range of bacterial spores is crucial for designing effective filtration systems, particularly in healthcare and laboratory settings. High-efficiency particulate air (HEPA) filters, for instance, are rated to capture particles as small as 0.3 micrometers, which falls within the spore size range. However, not all filters are created equal, and selecting the right one requires knowledge of spore dimensions. For example, in a hospital operating room, where preventing airborne contamination is critical, filters must be capable of trapping spores like those of *Clostridioides difficile*, which are around 1 micrometer in diameter. This ensures that even the smallest spores are captured, reducing infection risks.
From a biological perspective, the size of bacterial spores is a testament to their evolutionary efficiency. Their compact structure minimizes surface area, reducing exposure to harmful environmental factors like desiccation, radiation, and chemicals. This design allows spores to endure extreme conditions for years or even decades. For instance, *Bacillus anthracis* spores, which measure approximately 1 micrometer, have been known to survive in soil for centuries. This resilience underscores the importance of spore size in their ability to persist and re-emerge when conditions become favorable for growth.
Practical applications of knowing spore size extend to sterilization techniques as well. Methods like autoclaving rely on heat and pressure to kill spores, but their small size and robust structure make them more resistant than vegetative bacterial cells. For effective sterilization, temperatures of 121°C (250°F) and pressures of 15 psi must be maintained for at least 15 minutes to penetrate the spore’s protective layers. Industries such as food processing and pharmaceutical manufacturing must adhere to these parameters to ensure products are free from contamination. Understanding spore size helps optimize these processes, ensuring both safety and efficiency.
In summary, the size range of bacterial spores—0.5 to 1.5 micrometers—is a critical factor in their survival, detection, and eradication. Whether designing filtration systems, studying microbial resilience, or implementing sterilization protocols, this knowledge is indispensable. By appreciating the scale of these microscopic entities, we can better address the challenges they pose and harness their unique properties in various fields.
Does Milky Spore Stop Working? Understanding Its Long-Term Effectiveness
You may want to see also

Species Variation: Spore size varies among bacterial species, influenced by genetics and environment
Bacterial spores exhibit a remarkable diversity in size, a characteristic that is not random but deeply rooted in the species' genetic makeup and environmental interactions. For instance, *Bacillus subtilis* spores typically measure between 0.6 to 1.0 micrometers in diameter, while *Clostridium botulinum* spores can range from 0.5 to 0.8 micrometers. These variations are not merely trivial differences; they reflect adaptations that enhance survival in specific ecological niches. Genetic factors, such as the expression of spore coat proteins, play a pivotal role in determining spore dimensions. Environmental conditions, including nutrient availability and stress levels, further modulate these genetic influences, resulting in a spectrum of spore sizes across bacterial species.
Understanding the mechanisms behind spore size variation requires a closer look at the interplay between genetics and environment. In *Bacillus* species, for example, mutations in genes encoding spore coat layers can lead to smaller or larger spores, directly impacting their resistance to heat and desiccation. Conversely, environmental stressors like nutrient deprivation can trigger the production of thicker spore walls, increasing overall size. This dynamic relationship underscores the importance of both intrinsic and extrinsic factors in shaping spore morphology. By studying these variations, researchers can gain insights into how bacteria optimize their survival strategies in diverse habitats.
Practical applications of this knowledge extend to fields like food safety and medicine. For instance, knowing the typical spore size of *Clostridium perfringens* (0.8 to 1.0 micrometers) helps in designing filtration systems to prevent contamination in food processing. Similarly, in clinical settings, identifying spore size variations can aid in diagnosing infections caused by specific bacterial species. To leverage this information effectively, professionals should incorporate spore size data into risk assessment protocols and use microscopy techniques with calibrated scales for accurate measurements.
Comparatively, spore size variation also highlights evolutionary adaptations. Smaller spores, like those of *Bacillus anthracis*, may disperse more easily through air, facilitating transmission, while larger spores, such as those of *Clostridium tetani*, might store more nutrients for prolonged dormancy. This comparative analysis reveals how spore size is a critical trait shaped by selective pressures. For enthusiasts and researchers alike, documenting these variations across species can contribute to a growing database of bacterial spore characteristics, aiding in both academic research and practical applications.
In conclusion, the size of bacterial spores is a multifaceted trait influenced by genetic predispositions and environmental conditions. By examining species-specific variations, we uncover not only the biological mechanisms at play but also practical implications for industries and health sectors. Whether for scientific inquiry or applied solutions, recognizing and understanding these differences is essential for navigating the complex world of bacterial survival strategies.
Mimosa Reproduction: Unveiling the Truth About Spores and Propagation
You may want to see also

Measurement Methods: Techniques like microscopy and flow cytometry are used to determine spore size
Bacterial spores, renowned for their resilience, vary in size depending on the species, typically ranging from 0.5 to 1.5 micrometers in diameter. Accurately measuring these dimensions is crucial for fields like microbiology, medicine, and environmental science. Two primary techniques dominate this task: microscopy and flow cytometry, each offering distinct advantages and limitations.
Microscopy, the traditional gold standard, provides direct visualization of spores. Using light microscopy, researchers can observe spore morphology and estimate size by comparing them to calibrated grids or microbeads. For higher precision, electron microscopy offers nanometer-scale resolution, revealing intricate surface details. However, microscopy is time-consuming, requires skilled operators, and may introduce bias in spore selection. Additionally, sample preparation, such as fixation and staining, can alter spore dimensions, necessitating careful control measures.
Flow cytometry, a more modern approach, enables rapid analysis of large spore populations. This technique suspends spores in a fluid stream, passing them through a laser beam that scatters light proportional to their size. Detectors measure this scatter, generating size distributions. Flow cytometry excels in high-throughput applications, analyzing thousands of spores per second. It also allows simultaneous assessment of spore viability using fluorescent dyes. However, flow cytometry requires expensive equipment, specialized training, and careful calibration to avoid artifacts from spore aggregation or debris.
Choosing between microscopy and flow cytometry depends on the research question. For detailed morphological studies or small sample sizes, microscopy remains indispensable. In contrast, flow cytometry is ideal for statistical analyses, viability assessments, or screening large spore populations. Combining both techniques can provide complementary data, enhancing the accuracy and depth of spore size measurements.
Practical considerations include spore preparation, instrument calibration, and data interpretation. For microscopy, ensure spores are evenly distributed on slides and use appropriate magnification for accurate measurements. In flow cytometry, optimize sample concentration to prevent clogging and use size standards for calibration. Always consider the limitations of each method and validate results through replication and cross-verification. By mastering these techniques, researchers can unlock valuable insights into the size and characteristics of bacterial spores, contributing to advancements in various scientific disciplines.
Can Fungus Spores Survive on Rubber Surfaces? Uncovering the Truth
You may want to see also
Explore related products

Size and Survival: Smaller spores often exhibit greater resistance to environmental stresses
Bacterial spores, often measuring between 0.5 to 1.5 micrometers in diameter, are remarkably resilient structures. This size range is not arbitrary; it plays a critical role in their ability to withstand harsh environmental conditions. Smaller spores, in particular, exhibit greater resistance to stresses such as heat, radiation, and desiccation. This phenomenon is rooted in their reduced surface area-to-volume ratio, which minimizes exposure to damaging external factors while maintaining core protective mechanisms. For instance, spores of *Bacillus subtilis*, averaging 0.8 micrometers, are known to survive temperatures exceeding 100°C for extended periods, a feat larger spores often struggle to match.
The survival advantage of smaller spores extends beyond heat resistance. Their compact structure limits the ingress of harmful chemicals and UV radiation, which are more likely to penetrate larger, more porous structures. This is particularly evident in spores exposed to ionizing radiation, where smaller spores require significantly higher doses (up to 50% more) to achieve the same level of inactivation compared to their larger counterparts. For example, *Clostridium botulinum* spores, typically smaller than 1 micrometer, can survive radiation doses of 10 kGy, whereas larger spores from other species may succumb at 7 kGy. This resistance is crucial in industries like food preservation, where smaller spores pose a greater challenge to sterilization processes.
Practical implications of this size-survival relationship are evident in healthcare and food safety protocols. Smaller spores, such as those of *Geobacillus stearothermophilus* (0.6–0.8 micrometers), are often used as biological indicators in autoclave sterilization cycles. Their resistance ensures that if they are eliminated, all other pathogens will be as well. Conversely, larger spores, like those of *Bacillus atrophaeus* (1.0–1.5 micrometers), are less reliable for this purpose due to their comparatively lower resistance. To optimize sterilization, it’s essential to target the smallest spore size present in a given sample, typically by extending exposure times or increasing temperatures by 5–10°C.
From an evolutionary perspective, the smaller size of bacterial spores is a strategic adaptation. By minimizing their physical dimensions, spores reduce the metabolic demands required for maintenance, allowing them to remain dormant for decades or even centuries. This is particularly advantageous in nutrient-poor environments, where larger spores might exhaust their limited reserves more rapidly. For example, spores found in 25-million-year-old amber, estimated to be less than 1 micrometer in size, were successfully revived, highlighting the long-term survival benefits of smaller spores.
In summary, the size of bacterial spores is inversely proportional to their resistance to environmental stresses. Smaller spores, with their reduced surface area and efficient protective mechanisms, outperform larger spores in surviving extreme conditions. This principle has practical applications in sterilization protocols, where targeting the smallest spore size ensures comprehensive pathogen elimination. Understanding this relationship not only sheds light on bacterial survival strategies but also informs the development of more effective preservation and disinfection techniques.
Do All Milkweed Varieties Contain OE Spores? Unraveling the Myth
You may want to see also

Comparative Analysis: Bacterial spores are generally smaller than fungal spores but larger than viruses
Bacterial spores, fungal spores, and viruses represent distinct biological entities with varying sizes, each adapted to their unique survival strategies. Bacterial spores, typically ranging from 0.5 to 1.5 micrometers (μm) in diameter, are remarkably smaller than fungal spores, which can measure between 3 to 30 μm. This size difference is critical for understanding their environmental persistence and dispersal mechanisms. For instance, the smaller size of bacterial spores allows them to remain suspended in air longer, enhancing their ability to travel vast distances. In contrast, fungal spores, being larger, tend to settle more quickly but are better equipped to withstand harsh conditions due to their thicker cell walls.
To put this into perspective, consider the practical implications for air filtration systems. HEPA filters, designed to capture particles as small as 0.3 μm, are highly effective against bacterial spores but may struggle with larger fungal spores, which require more robust filtration methods. This size disparity also influences their detection and control in clinical and industrial settings. For example, while bacterial spores can be easily aerosolized and detected using air samplers, fungal spores often require surface sampling due to their quicker settling.
Viruses, on the other hand, are significantly smaller than both bacterial and fungal spores, typically ranging from 20 to 400 nanometers (nm). This minuscule size allows viruses to penetrate deeper into the respiratory system, posing unique challenges for infection control. For instance, N95 respirators, effective against particles as small as 0.1 μm, are recommended for viral protection, whereas bacterial spores may require less stringent measures. Understanding these size differences is crucial for tailoring disinfection protocols, as viral inactivation often requires more aggressive methods, such as UV-C light or chemical disinfectants, compared to the heat or chemical treatments typically used for bacterial spores.
From a comparative standpoint, the size hierarchy—viruses < bacterial spores < fungal spores—dictates their interactions with the environment and hosts. Bacterial spores, occupying the middle ground, balance mobility and resilience. Their size allows them to evade many filtration systems while remaining robust enough to survive extreme conditions, such as desiccation or radiation. This makes them particularly challenging to eradicate in healthcare and food processing settings, where they can contaminate surfaces and equipment. In contrast, fungal spores, though larger, are less likely to remain airborne, limiting their spread but necessitating targeted cleaning strategies to remove settled particles.
In practical terms, this comparative analysis informs the design of sterilization and filtration systems. For example, autoclaves, which use steam under pressure, are effective against bacterial spores due to their ability to penetrate the spore’s protective layers, but they may be less effective against fungal spores, which require higher temperatures or longer exposure times. Similarly, understanding the size differences helps in selecting appropriate personal protective equipment (PPE). While surgical masks may suffice for bacterial spore protection, fungal spore exposure may require respirators with higher filtration efficiency, and viral threats demand the use of N95 or higher-grade masks. By recognizing these size-based distinctions, professionals can implement more targeted and effective control measures.
Exploring Spore Diversity: Do All Spores Possess a Spore Coat?
You may want to see also
Frequently asked questions
Bacterial spores are typically smaller than the vegetative bacterial cells they form from, usually ranging from 0.3 to 1.0 micrometers (μm) in diameter, while the bacteria themselves can be 1 to 5 μm in length.
The average size of a bacterial spore is approximately 0.5 to 0.7 micrometers (μm) in diameter, though this can vary depending on the bacterial species.
Yes, bacterial spores are visible under a light microscope, but they appear as small, refractile bodies within or next to the bacterial cell, often requiring staining techniques for better visualization.
Bacterial spores are significantly larger than viruses, which typically range from 0.02 to 0.3 micrometers (μm). Spores are generally 0.3 to 1.0 μm in diameter, making them 10 to 50 times larger than most viruses.
No, the size of bacterial spores varies depending on the species. For example, *Bacillus* spores are typically 0.6 to 0.8 μm in diameter, while *Clostridium* spores can be slightly larger, around 0.5 to 1.0 μm.

























